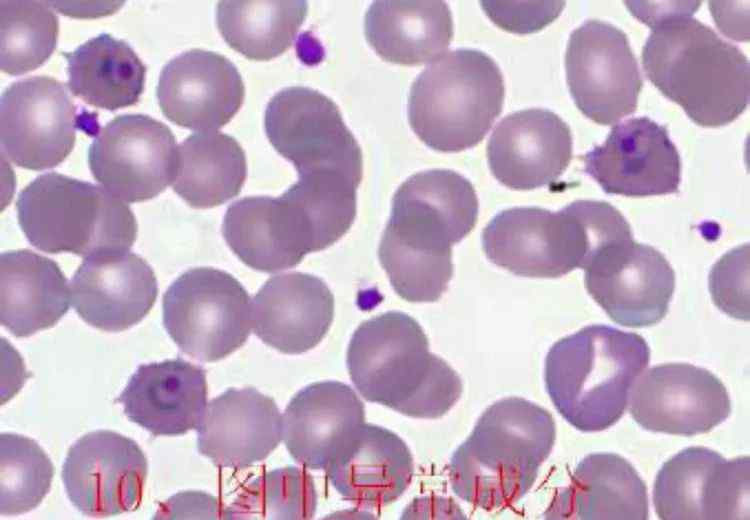

作者:刘四川省~西昌市人民医院
整理:王赢~北京市丰台区医院
图片来源:君安医疗细胞平台1基层单位
下午好,老师们。今天站台上有/[/k0/】。我带了一些照片。请积极参与。

供你参考。
1个蛋白膜(未受精的蛔虫卵)
利什曼原虫;利什曼原虫
3中心体/空囊泡(人芽囊原虫)
4花粉
5个细胞(小肠纤毛虫)
6巴别西亚/巴别西亚
7生殖原基(粪蛔虫)
8胚膜(绦虫卵)
9个透明蛋塞(鞭虫蛋)
10个卵形环状疟疾
11人芽囊原虫(粗颗粒)
12个钩虫卵(包括钩虫幼虫)
感谢您的参与!
1.《寄生虫图片 寄生虫图片》援引自互联网,旨在传递更多网络信息知识,仅代表作者本人观点,与本网站无关,侵删请联系页脚下方联系方式。
2.《寄生虫图片 寄生虫图片》仅供读者参考,本网站未对该内容进行证实,对其原创性、真实性、完整性、及时性不作任何保证。
3.文章转载时请保留本站内容来源地址,https://www.lu-xu.com/guonei/1584561.html


